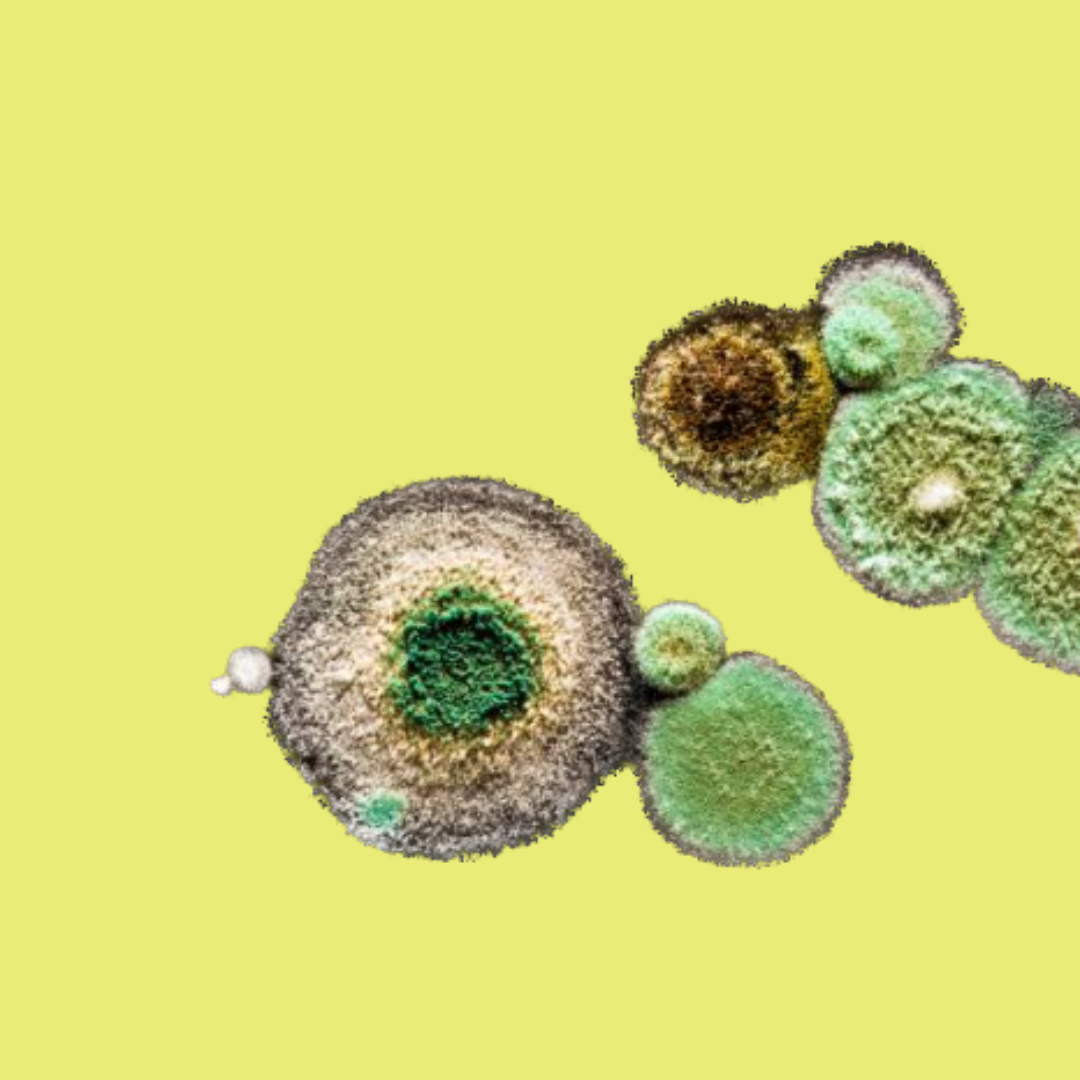
Magnified mold spores on a yellow background.

coaching
facilitation
systems change
bring your furrowed brow, your tangled team dynamics, your awkward questions
-

Coach
Coaching for when you don’t know who you are, what you want, or where to go.
-

Facilitate
Facilitating for the messy uncomfortable stuff that feels difficult.
-
Change
Systems change for complex humans doing complex things.
-

Grow
Capacity-building for the reality of an unpredictable world in flux.
tending to complexity together
You won’t find quick fixes here.
Instead you’ll find a space where mess is welcomed, discomfort is held with care, and transformation becomes possible.
Complex predicaments don’t respond to reductive solutions. Different capacities are needed.
Learn to slow down, sense the patterns, and compost what no longer serves.
In the shift from 'fixing' individuals and problems to healing the systems that give rise to them, freshness emerges.
Out beyond ideas of wrongdoing & rightdoing, there is a field. I'll meet you there.
Out beyond ideas of wrongdoing & rightdoing, there is a field. I'll meet you there.
-Rumi